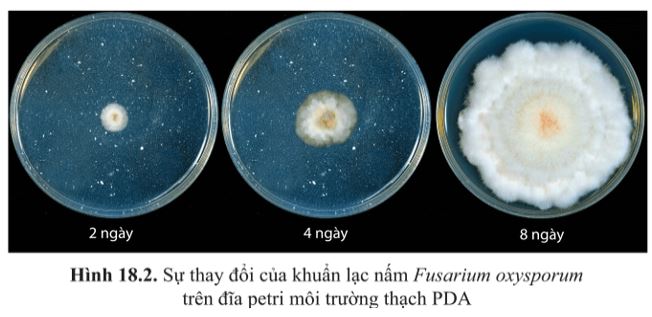
Giải Sinh 10 Bài 18

Giải Sinh 10 Bài 18: Sinh trưởng và sinh sản ở vi sinh vật CD
Giải Sinh 10 Bài 18
Giải Sinh 10 Bài 18: Sinh trưởng và sinh sản ở vi sinh vật CD được VnDoc.com sưu tầm và xin gửi tới bạn đọc. Mời các bạn cùng theo dõi chi tiết bài viết dưới đây nhé.
I. Sinh trưởng của vi sinh vật
Câu 1 trang 109 SGK Sinh 10 CD
Quan sát hình 18.2 và nhận xét sự thay đổi của khuẩn lạc nấm (quần thể nấm) Fusarium oxysporum theo thời gian. Vì sao có sự thay đổi này?
Lời giải
- Nhận xét sự thay đổi của khuẩn lạc nấm (quần thể nấm) Fusarium oxysporum theo thời gian: Khuẩn lạc của nấm lan rộng và phủ khắp bề mặt đĩa petri theo thời gian.
- Giải thích: Sự thay đổi kích thước khuẩn lạc là do quần thể nấm sinh sản nhanh tăng lên về số lượng tế bào.
Câu 2 trang 110 SGK Sinh 10 CD
Từ các thông tin mô tả trong hình 18.3 và bảng 18.1, cho biết:

a) Vì sao ở pha tiềm phát, chất dinh dưỡng đầy đủ mà mật độ quần thể vi khuẩn gần như không thay đổi?
b) Sinh khối vi khuẩn đạt cao nhất vào thời điểm nào? Giải thích.
c) Vì sao số tế bào chết trong quần thể vi khuẩn tăng dần từ pha cân bằng đến pha suy vong?
Lời giải
- Ở pha tiềm phát, chất dinh dưỡng đầy đủ mà mật độ quần thể vi khuẩn gần như không thay đổi vì: Ở pha này, vi khuẩn chưa phân chia mà mới bắt đầu thích ứng dần với môi trường, tổng hợp các enzyme trao đổi chất và DNA, chuẩn bị cho quá trình phân bào.
- Sinh khối vi khuẩn đạt cao nhất vào cuối pha lũy thừa, đầu pha cân bằng vì: Vào cuối pha lũy thừa, đầu pha cân bằng, mật độ tế bào vi khuẩn trong quần thể tăng nhanh, quần thể đạt tốc độ sinh trưởng tối đa, số lượng tế bào tăng theo lũy thừa và đạt đến cực đại.
- Số tế bào chết trong quần thể vi khuẩn tăng dần từ pha cân bằng đến pha suy vong do dinh dưỡng thiếu hụt và cạn kiệt, các chất độc hại cho sự sinh trưởng của quần thể vi khuẩn tích lũy tăng dần.
II. Sinh sản của vi sinh vật
Câu 3 trang 111 SGK Sinh 10 CD
Sinh sản của vi sinh vật có vai trò gì đối với sự sinh trưởng của quần thể vi sinh vật?
Lời giải
Sinh trưởng của quần thể vi sinh vật là sự tăng lên về mặt số lượng tế bào trong quần thể mà sinh sản của vi sinh vật là quá trình tạo nên các tế bào vi sinh vật mới → Sinh sản chính là cơ sở để tạo nên sự sinh trưởng của quần thể vi sinh vật.
Câu 4 trang 111 SGK Sinh 10 CD
Sinh sản ở vi sinh vật nhân sơ có giống với vi sinh vật nhân thực không?
Lời giải
- Giống nhau: Sinh sản ở vi sinh vật nhân sơ và vi sinh vật nhân thực đều là sự tạo ra tế bào vi sinh vật mới; đều có các hình thức là phân đôi, nảy chồi, hình thành bào tử vô tính.
- Khác nhau: Ở vi sinh vật nhân sơ chỉ có hình thức sinh sản vô tính, ở vi sinh vật nhân thực có cả hình thức sinh sản vô tính và hình thức sinh sản hữu tính (sinh sản bằng bào tử hữu tính).
Câu 5 trang 112 SGK Sinh 10 CD
Quan sát hình 18.7 và cho biết nảy chồi của nấm men có khác gì so với nảy chồi ở vi khuẩn?

Lời giải
Điểm khác nhau giữa nảy chồi của nấm men so với nảy chồi ở vi khuẩn:
- Ở nấm men, các chồi mọc lên trực tiếp không có các ống rỗng như nảy chồi ở vi khuẩn.
- Sự phân chia vật chất di truyền trong nảy chồi ở nấm men theo kiểu phân bào có thoi vô sắc còn ở vi khuẩn phân bào không có thoi vô sắc.
III. Các yếu tố ảnh hưởng đến sinh trưởng của vi sinh vật
Câu 6 trang 113 SGK Sinh 10 CD
Thí nghiệm đánh giá ảnh hưởng của nguồn dinh dưỡng (đường sucrose) đến sinh trưởng của nấm men rượu S. cerevisiae được bố trí trong ba bình tam giác đều chứa 100mL dung dịch 1% (NH4)SO4 và bổ sung thêm: 0,5 g sucrose (bình 1); 106 tế bào nấm men (bình 2); 5 g sucrose và 106 tế bào nấm men (bình 3). Sau hai ngày để ở nhiệt độ phòng, thu được kết quả như hình 18.10. Dựa vào cách bố trí thí nghiệm và kết quả thí nghiệm cho biết: Tại sao bình 3 có hiện tượng đục lên sau hai ngày còn bình 1 và 2 không có hiện tượng này.

Lời giải
- Bình 3 có hiện tượng đục lên là do: Bình 3 có chủng nấm men và có nguồn dinh dưỡng là đường sucrose nên nấm men rượu sinh trưởng mạnh mẽ. Mật độ tế bào nấm men trong bình tăng lên làm đục dung dịch trong bình.
- Bình 1 thiếu chủng nấm men, bình 2 thiếu nguồn carbon hữu cơ nên không có hiện tượng nấm men sinh trưởng mạnh mẽ dẫn đến làm đục dung dịch trong bình.
Câu 7 trang 114 SGK Sinh 10 CD
Nếu bổ sung thêm một lượng lớn NaOH (ví dụ khoảng 4 g) vào bình 3 trước khi làm thí nghiệm (hình 18.10) thì kết quả thí nghiệm có thay đổi không? Vì sao?

Lời giải
- Nếu bổ sung thêm một lượng lớn NaOH vào bình 3 trước khi làm thí nghiệm thì kết quả thí nghiệm có thay đổi.
- Vì: Khi thêm NaOH vào bình 3 sẽ làm thay đổi pH (pH tăng) mà nấm men sinh trưởng tốt trong môi trường acid (pH là 4,5 – 5,0). Do đó, khi thêm lượng lớn NaOH, có thể gây chết nấm men.
Câu 8 trang 114 SGK Sinh 10 CD
Nếu bình 3 trong thí nghiệm ở hình 18.10 được để ở 70oC (thay cho nhiệt độ phòng) thì kết quả thí nghiệm sau hai ngày thay đổi như thế nào? Giải thích.
Lời giải
- Nếu bình 3 trong thí nghiệm ở hình 18.10 được để ở 70oC (thay cho nhiệt độ phòng) thì kết quả thí nghiệm sau hai ngày có sự thay đổi: Độ đục của bình 3 không được như trong thí nghiệm ban đầu.
- Vì: Nấm men rượu sinh trưởng tốt nhất ở nhiệt độ khoảng 28 – 32oC. Bởi vậy, nếu tăng nhiệt độ lên 70oC có thể khiến nấm men rượu giảm tốc độ sinh trưởng thậm chí là gây chết.
Câu 9 trang 115 SGK Sinh 10 CD
Kể tên một số thuốc kháng sinh trên thị trường mà em biết. Nêu ý nghĩa của việc dùng thuốc kháng sinh trong điều trị bệnh nhiễm khuẩn.
Lời giải
- Các thuốc kháng sinh trên thị trường như penicilin, tetracylin, amocxicilin, phenicol,lincosamid,...
- Ý nghĩa của việc dùng thuốc kháng sinh trong điều trị bệnh nhiễm khuẩn: Thuốc kháng sinh là chế phẩm có khả năng tiêu diệt hoặc ức chế đặc hiệu sự sinh trưởng của một hoặc một vài nhóm vi sinh vật giúp điều trị các bệnh gây ra bởi vi khuẩn, cứu sống nhiều người và thúc đẩy ngành chăn nuôi phát triển. Tuy nhiên, không nên lạm dụng thuốc kháng sinh sẽ gây nhờn thuốc, khi đó điều trị bệnh không còn hiệu quả.
Trên đây VnDoc.com vừa gửi tới bạn đọc bài viết Giải Sinh 10 Bài 18: Sinh trưởng và sinh sản ở vi sinh vật CD. Hi vọng qua bài viết này bạn đọc có thêm tài liệu để học tập tốt hơn môn Sinh học 10 CD. Mời các bạn cùng tham khảo thêm tài liệu học tập môn Toán 10 CD...